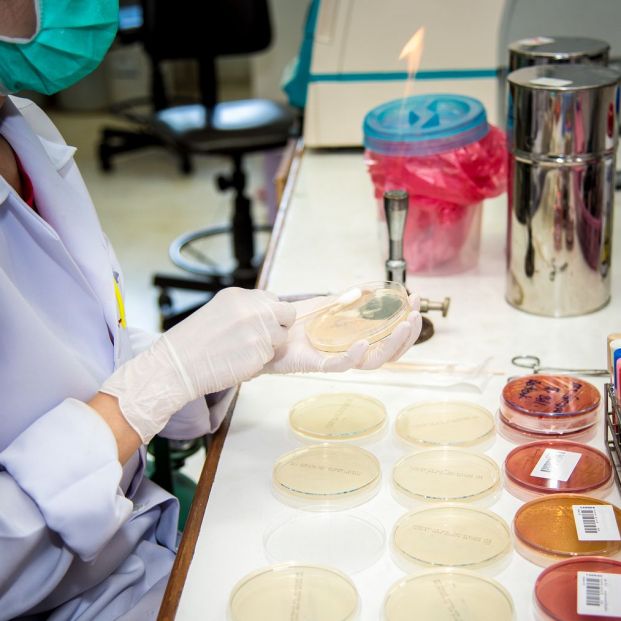
Septicemia Septicemia

¿Qué es la septicemia y qué incidencia tiene en las personas mayores?
Los casos de la también llamada sepsis han aumentado debido al envejecimiento de la población

Esta es una de las conclusiones a las que ha llegado el Grupo de Patologías Infecciosas de la Sociedad Española de Medicina de Urgencias y Emergencias (@SEMES_) en su, recientemente celebrado, Congreso Nacional. La septicemia es una enfermedad grave que siempre tiene su origen en un proceso infeccioso y en la respuesta “agresiva” en exceso del propio sistema inmunitario, que reacciona intentando defenderse de la infección y acaba incrementando el daño en el organismo.
Causas, síntomas y medidas frente a la sepsis
Se calcula que en España fallecen cada año unas 17.000 personas a causa de la septicemia. Los expertos consideran que el aumento en la esperanza de vida de la población y la mayor supervivencia de los pacientes que sufren algún tipo de cáncer son dos de las causas que podrían explicar el incremento en las cifras.
La sepsis comienza por una infección localizada, puede tratarse de algún tipo de infección urinaria (muy común), de tipo respiratorio o abdominal. Esa infección se puede extender, con mayor o menor rapidez e intensidad, al resto del organismo y afectar a órganos vitales como el hígado o los riñones, provocando así una situación de máxima gravedad.
Entre los grupos de riesgo más proclives a la septicemia, se encuentra el de las personas mayores, especialmente aquellas que pueden sufrir una enfermedad crónica. Fiebre, somnolencia, desorientación o náuseas son algunos de los síntomas que pueden ser un indicio del principio de una sepsis, ante la que hay que actuar con rapidez acudiendo a un servicio hospitalario de urgencia.
Es esencial iniciar cuanto antes el tratamiento antibiótico que logre frenar la expansión de la infección. En este sentido, son muchos los hospitales de las distintas comunidades autónomas que forman parte del Código Sepsis del Ministerio de Sanidad, Consumo y Bienestar (@sanidadgob), un documento que recoge una serie de medidas prácticas, propuestas por profesionales de distintos ámbitos de la Sanidad, que permiten frenar la incidencia de esta enfermedad y sus consecuencias.
Como ejemplo de la eficacia de estas medidas, el Hospital Clínico San Carlos de Madrid (@HospClinico), gracias a la atención temprana frente a septicemia, redujo el pasado año en un 22% la mortalidad en los pacientes que fueron atendidos por esta enfermedad.